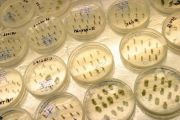

由Admin上传
来自医学百科
本特殊页面展示所有上传的文件。
| 日期 | 名称 | 缩略图 | 尺寸 | 说明 | 版本 |
|---|---|---|---|---|---|
| 2014年3月17日 (一) 15:53 | Bkflm.jpg (文件) |  |
12 KB | 1 | |
| 2014年3月17日 (一) 15:53 | Bkojq.jpg (文件) |  |
40 KB | 1 | |
| 2014年3月17日 (一) 15:53 | Bk4pb.jpg (文件) |  |
7 KB | 1 | |
| 2014年3月17日 (一) 15:53 | Bkisa.jpg (文件) |  |
20 KB | 1 | |
| 2014年3月17日 (一) 15:52 | 大肠杆菌10000x.jpg (文件) | 生成缩略图出错:无法找到文件 |
92 KB | 2 | |
| 2014年3月17日 (一) 15:52 | Bk4v3.jpg (文件) |  |
70 KB | 1 | |
| 2014年3月17日 (一) 15:52 | Bkj2m.jpg (文件) |  |
50 KB | 1 | |
| 2014年3月17日 (一) 15:52 | 红丝带.png (文件) |  |
26 KB | 2 | |
| 2014年3月17日 (一) 15:52 | Bko97.jpg (文件) |  |
177 KB | 1 | |
| 2014年3月17日 (一) 15:52 | Bkodv.jpg (文件) |  |
34 KB | 1 | |
| 2014年3月17日 (一) 15:52 | Bk9gj.jpg (文件) |  |
42 KB | 1 | |
| 2014年3月17日 (一) 15:51 | Bkkoo.jpg (文件) |  |
51 KB | 1 | |
| 2014年3月17日 (一) 15:51 | Glmg26jy.jpg (文件) |  |
196 KB | 1 | |
| 2014年3月17日 (一) 15:51 | Bkcw9.jpg (文件) |  |
9 KB | 1 | |
| 2014年3月17日 (一) 15:51 | Bkjbx.jpg (文件) |  |
162 KB | 1 | |
| 2014年3月17日 (一) 15:51 | Bkijt.jpg (文件) |  |
60 KB | 1 | |
| 2014年3月17日 (一) 15:50 | Bk9l7.jpg (文件) |  |
37 KB | 1 | |
| 2014年3月17日 (一) 15:50 | Bk2zx.jpg (文件) |  |
63 KB | 1 | |
| 2014年3月17日 (一) 15:50 | Bkbb2.jpg (文件) |  |
3 KB | 1 | |
| 2014年3月17日 (一) 15:50 | Bkox6.jpg (文件) |  |
77 KB | 1 | |
| 2014年3月17日 (一) 15:50 | Bk7pn.jpg (文件) |  |
122 KB | 1 | |
| 2014年3月17日 (一) 15:50 | Bkqtb.jpg (文件) |  |
35 KB | 1 | |
| 2014年3月17日 (一) 15:49 | Bk7tf.jpg (文件) |  |
11 KB | 1 | |
| 2014年3月17日 (一) 15:49 | Bkd0e.jpg (文件) |  |
26 KB | 1 | |
| 2014年3月17日 (一) 15:49 | Bko98.jpg (文件) |  |
175 KB | 1 | |
| 2014年3月17日 (一) 15:49 | Bk1ho.jpg (文件) |  |
13 KB | 1 | |
| 2014年3月17日 (一) 15:49 | Bkbsf.jpg (文件) |  |
54 KB | 1 | |
| 2014年3月17日 (一) 15:48 | Bkoat.jpg (文件) |  |
125 KB | 1 | |
| 2014年3月17日 (一) 15:48 | Bkp9b.jpg (文件) |  |
19 KB | 1 | |
| 2014年3月17日 (一) 15:48 | Bkkiw.jpg (文件) |  |
34 KB | 1 | |
| 2014年3月17日 (一) 15:48 | Bkpua.jpg (文件) |  |
69 KB | 1 | |
| 2014年3月17日 (一) 15:48 | Bk97d.jpg (文件) |  |
89 KB | 1 | |
| 2014年3月17日 (一) 15:48 | Bko2k.jpg (文件) |  |
143 KB | 1 | |
| 2014年3月17日 (一) 15:48 | Bkqhv.jpg (文件) |  |
13 KB | 1 | |
| 2014年3月17日 (一) 15:47 | Bkkur.jpg (文件) |  |
14 KB | 1 | |
| 2014年3月17日 (一) 15:47 | Bkb2x.jpg (文件) |  |
106 KB | 1 | |
| 2014年3月17日 (一) 15:47 | Bkpjk.jpg (文件) |  |
78 KB | 1 | |
| 2014年3月17日 (一) 15:47 | Bkk5x.jpg (文件) |  |
40 KB | 1 | |
| 2014年3月17日 (一) 15:47 | Bkapk.jpg (文件) |  |
27 KB | 1 | |
| 2014年3月17日 (一) 15:47 | Bkgph.jpg (文件) |  |
54 KB | 1 | |
| 2014年3月17日 (一) 15:46 | Bkkw9.jpg (文件) |  |
31 KB | 1 | |
| 2014年3月17日 (一) 15:46 | Bkqe6.jpg (文件) |  |
36 KB | 1 | |
| 2014年3月17日 (一) 15:46 | Bkd1q.jpg (文件) |  |
216 KB | 1 | |
| 2014年3月17日 (一) 15:46 | Bkksx.jpg (文件) |  |
244 KB | 1 | |
| 2014年3月17日 (一) 15:46 | Bkoep.jpg (文件) |  |
173 KB | 1 | |
| 2014年3月17日 (一) 15:46 | Bkqja.jpg (文件) |  |
70 KB | 1 | |
| 2014年3月17日 (一) 15:46 | Bk1lz.jpg (文件) |  |
73 KB | 1 | |
| 2014年3月17日 (一) 15:45 | 粉刺.jpg (文件) | 生成缩略图出错:无法找到文件 |
32 KB | 2 | |
| 2014年3月17日 (一) 15:45 | Bkehc.jpg (文件) | |
156 KB | 1 | |
| 2014年3月17日 (一) 15:45 | Bkg7y.jpg (文件) |  |
17 KB | 1 |